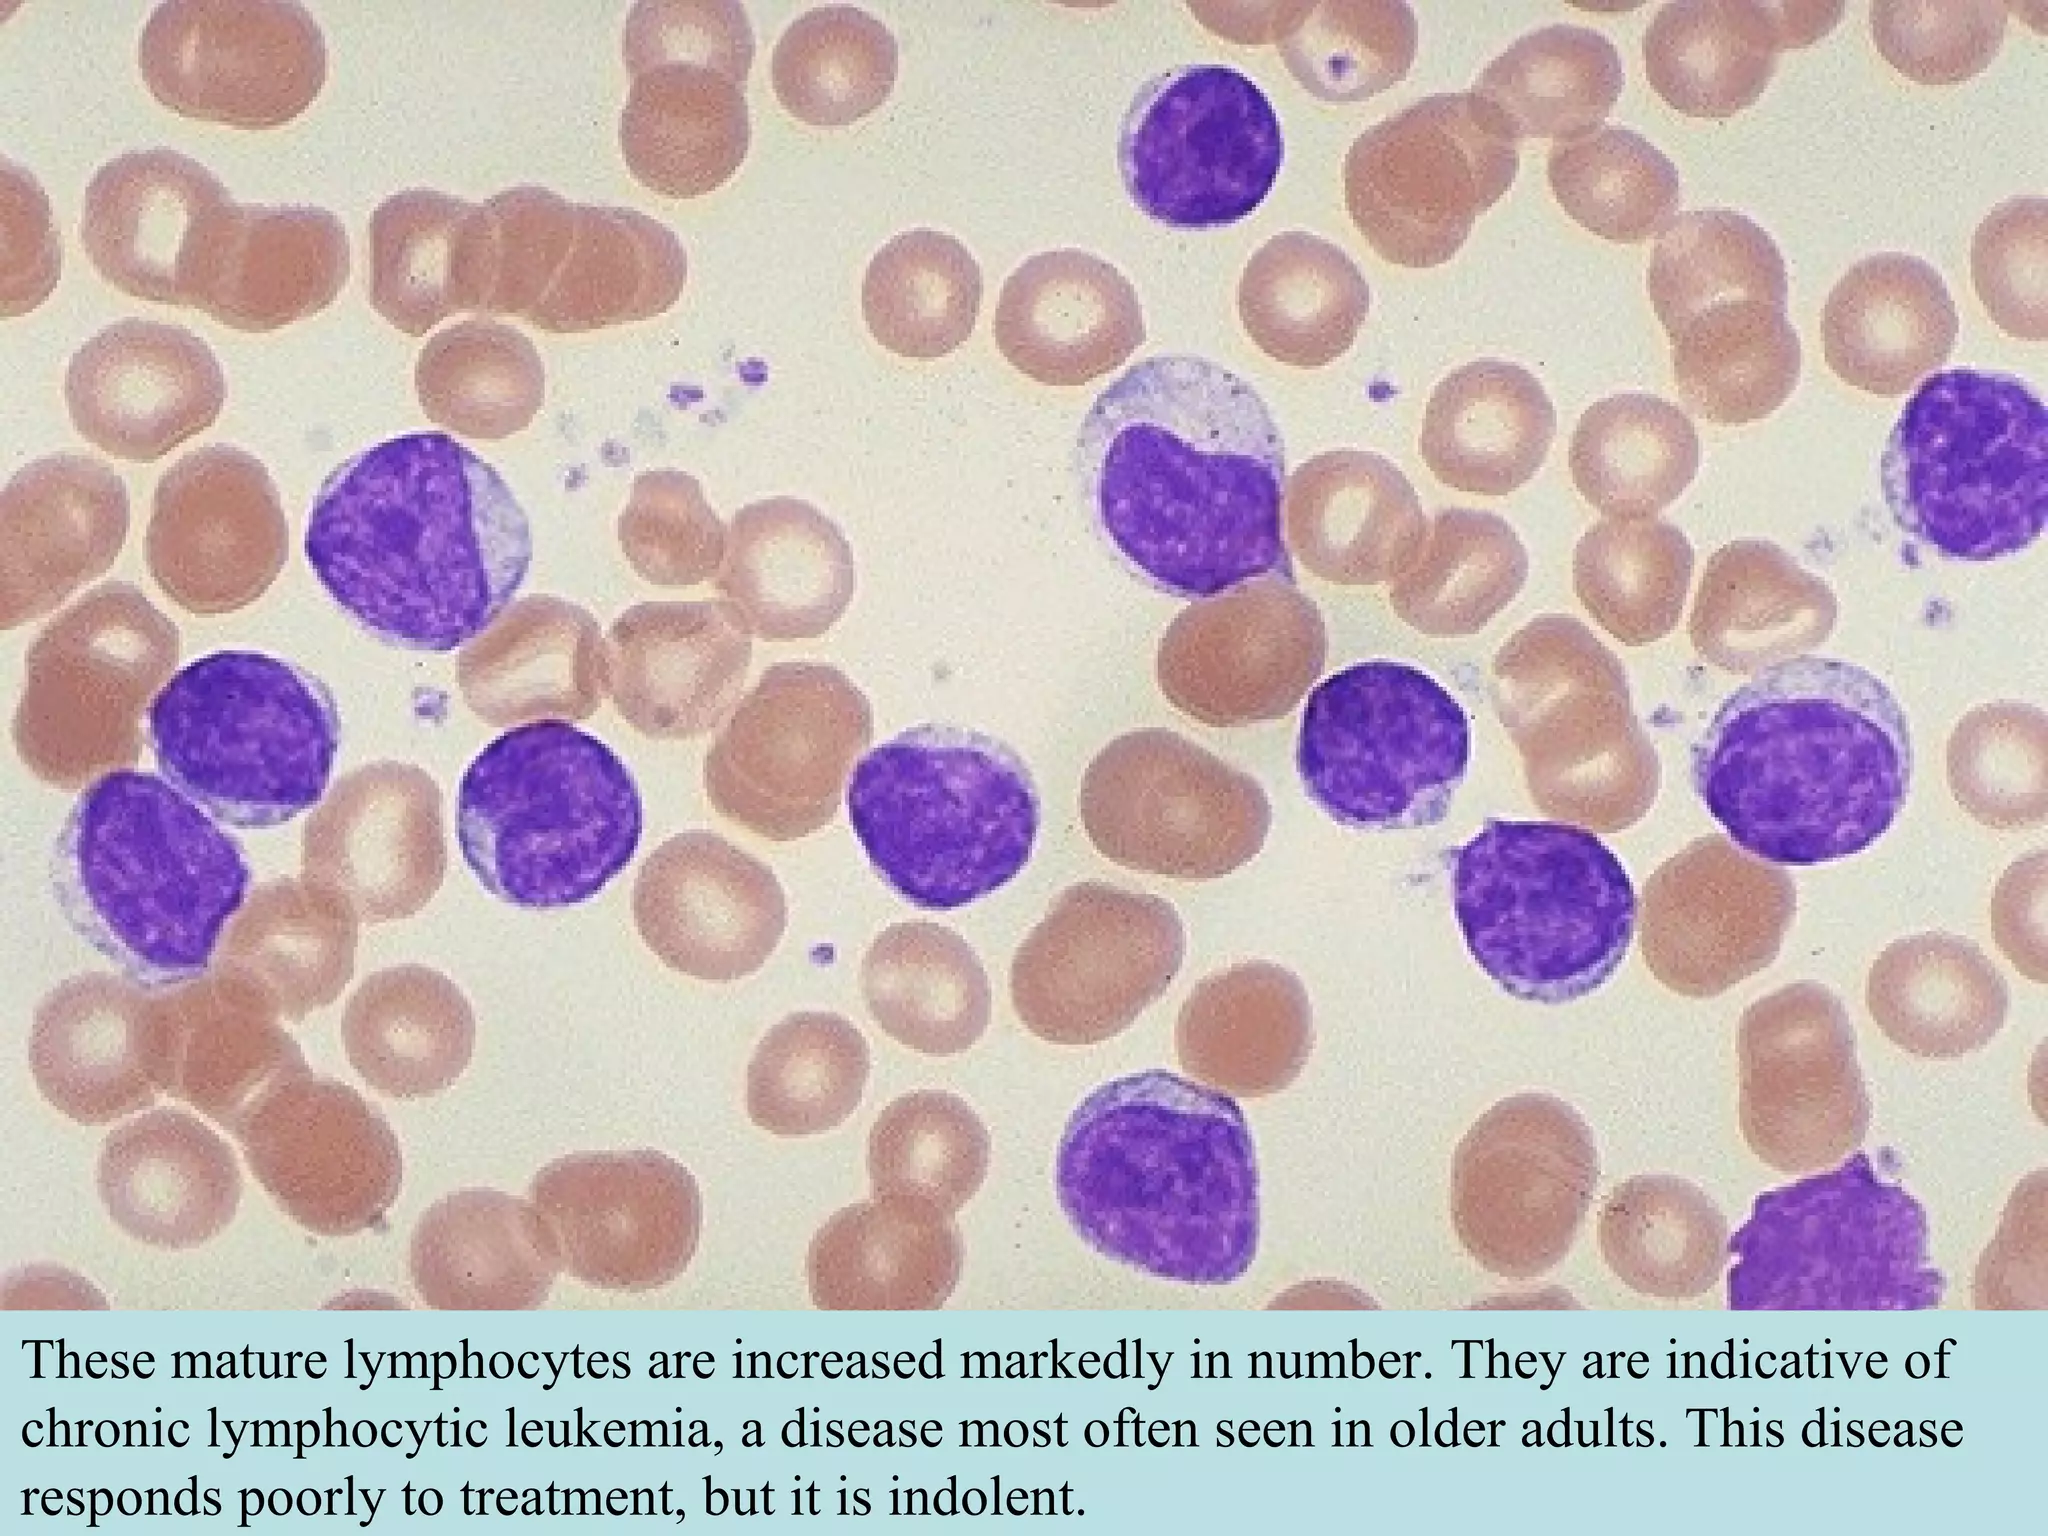
These mature lymphocytes are increased markedly in number. They are indicative of
chronic lymphocytic leukemia, a disease most often seen in older adults. This disease
responds poorly to treatment, but it is indolent.
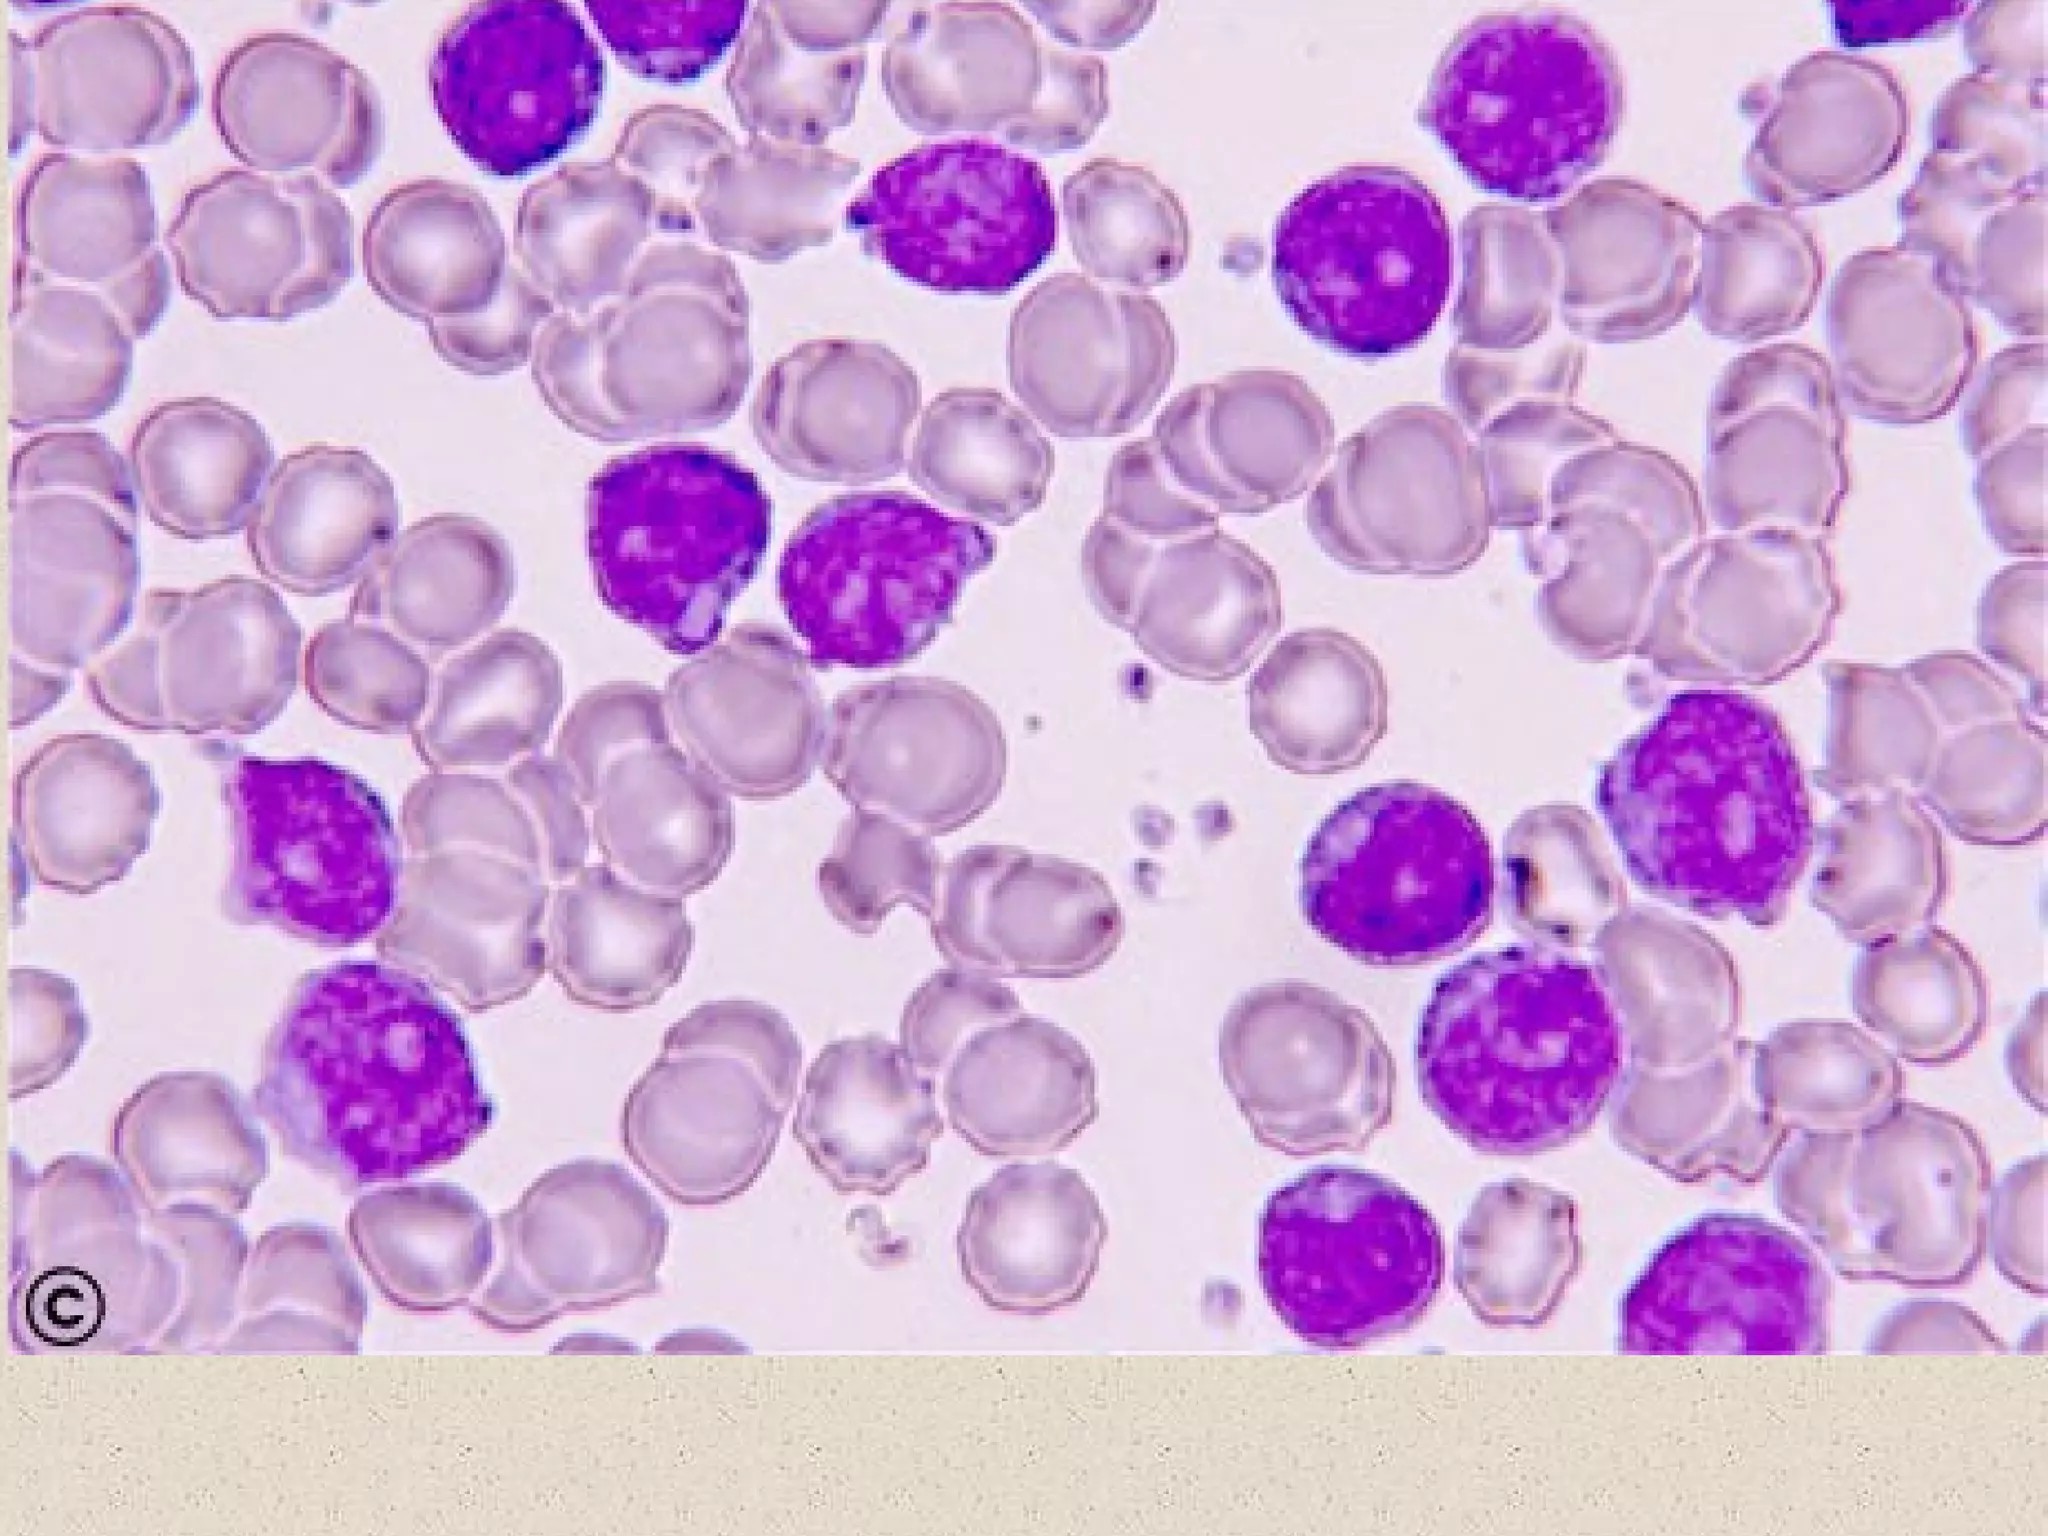
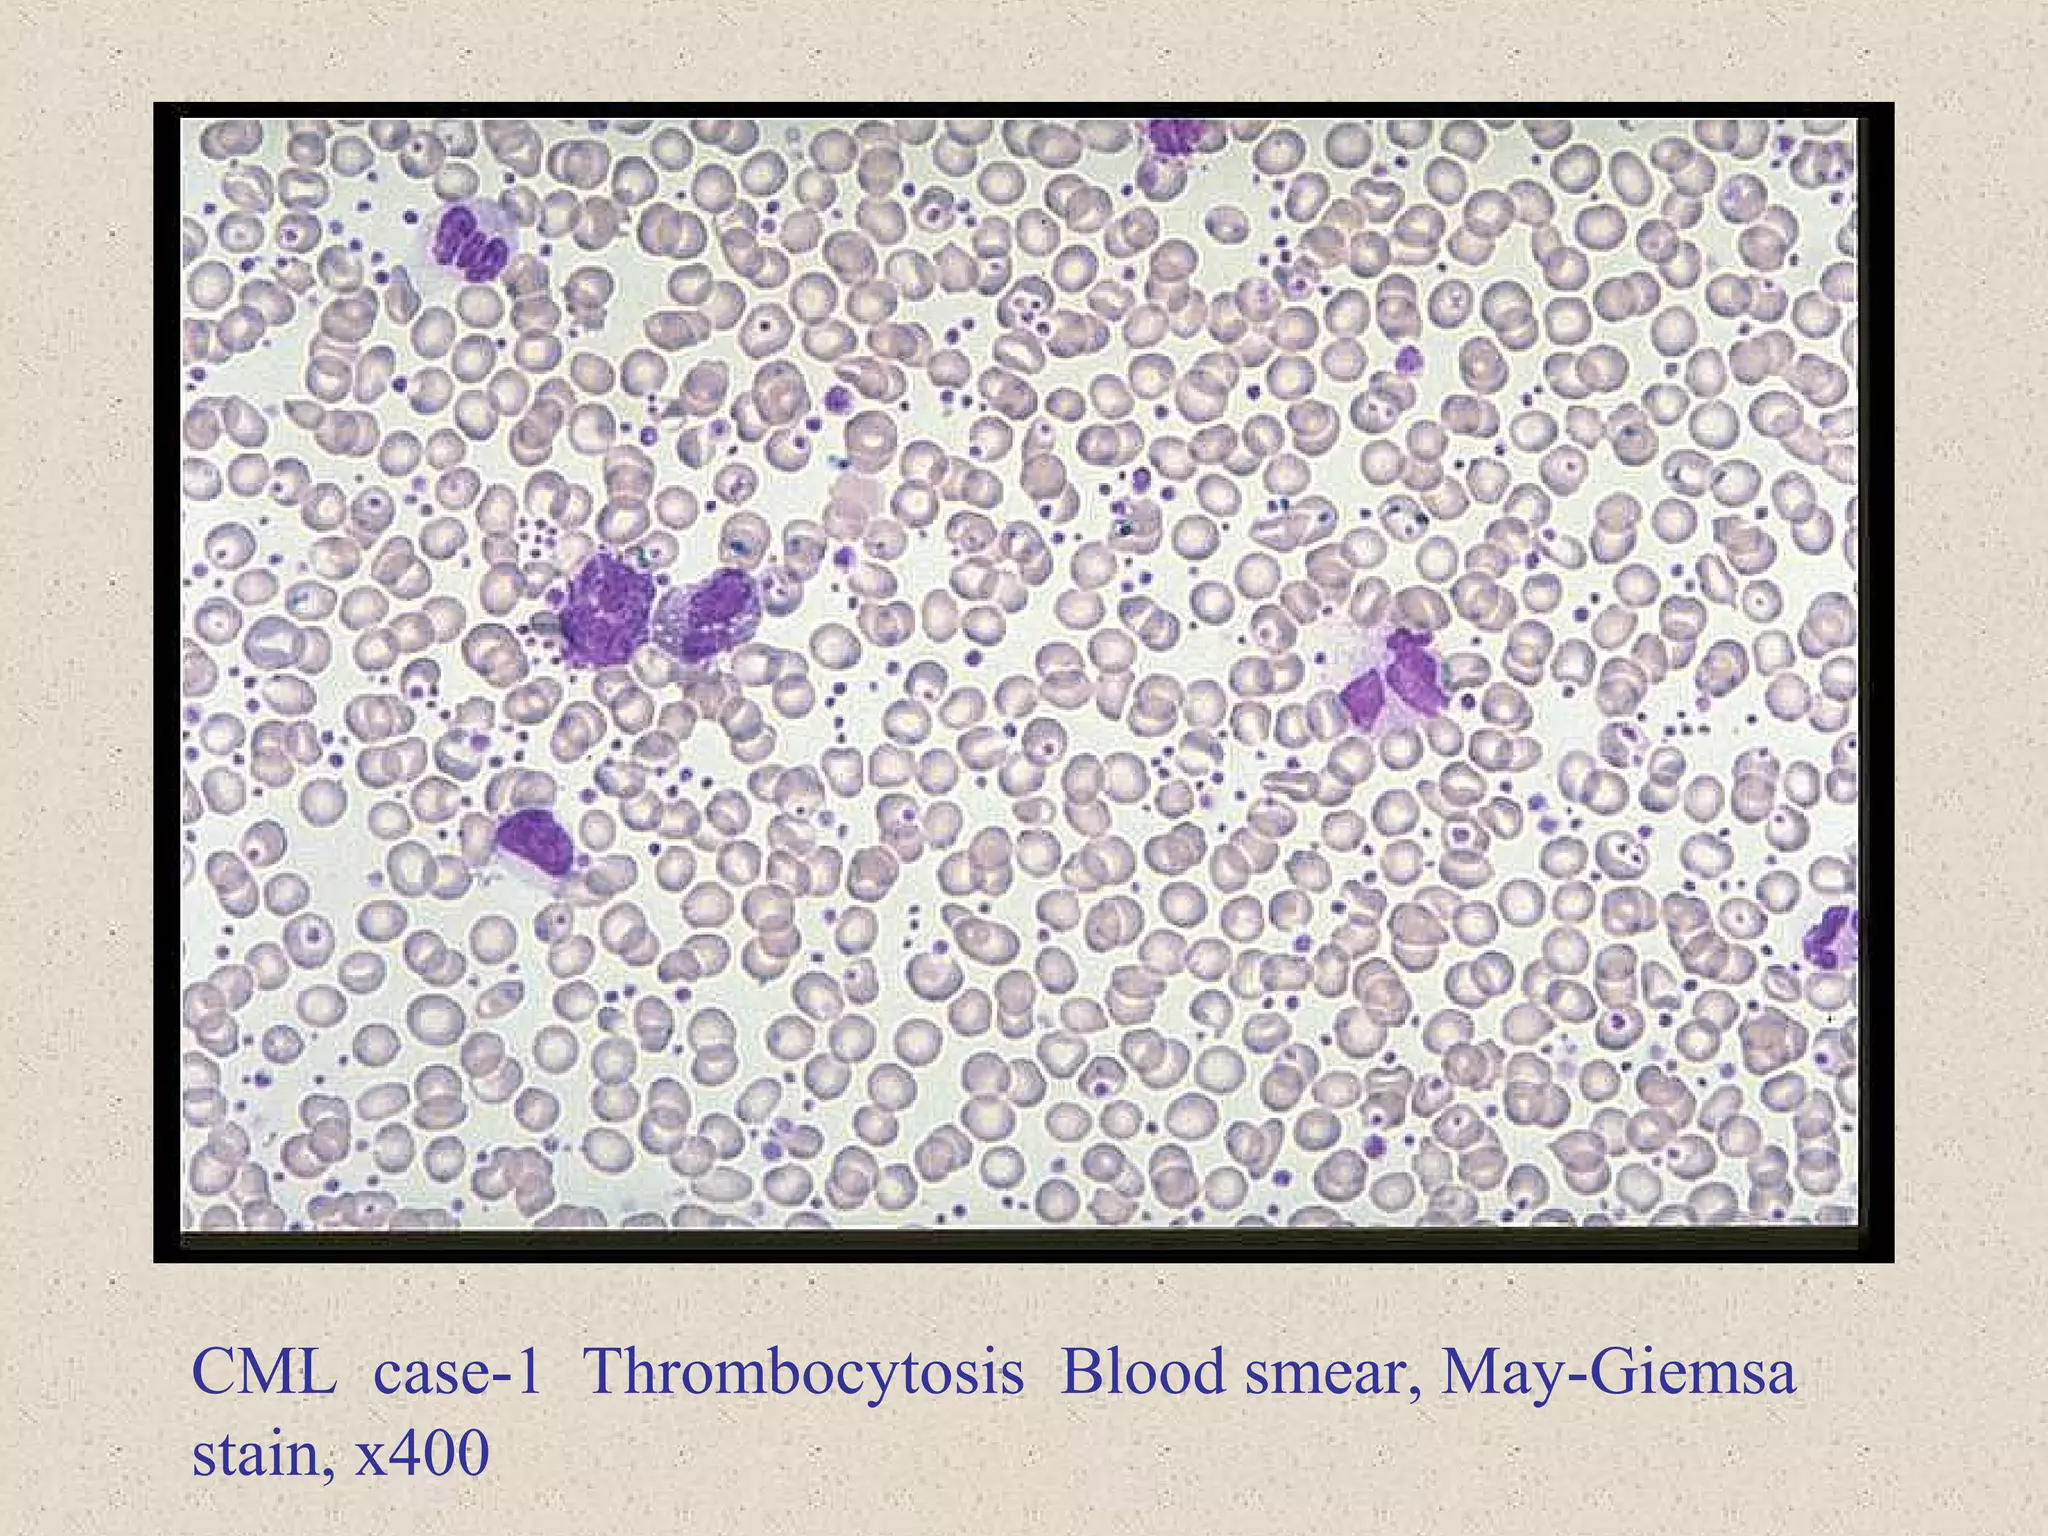
CML case-1 Thrombocytosis Blood smear, May-Giemsa
stain, x400
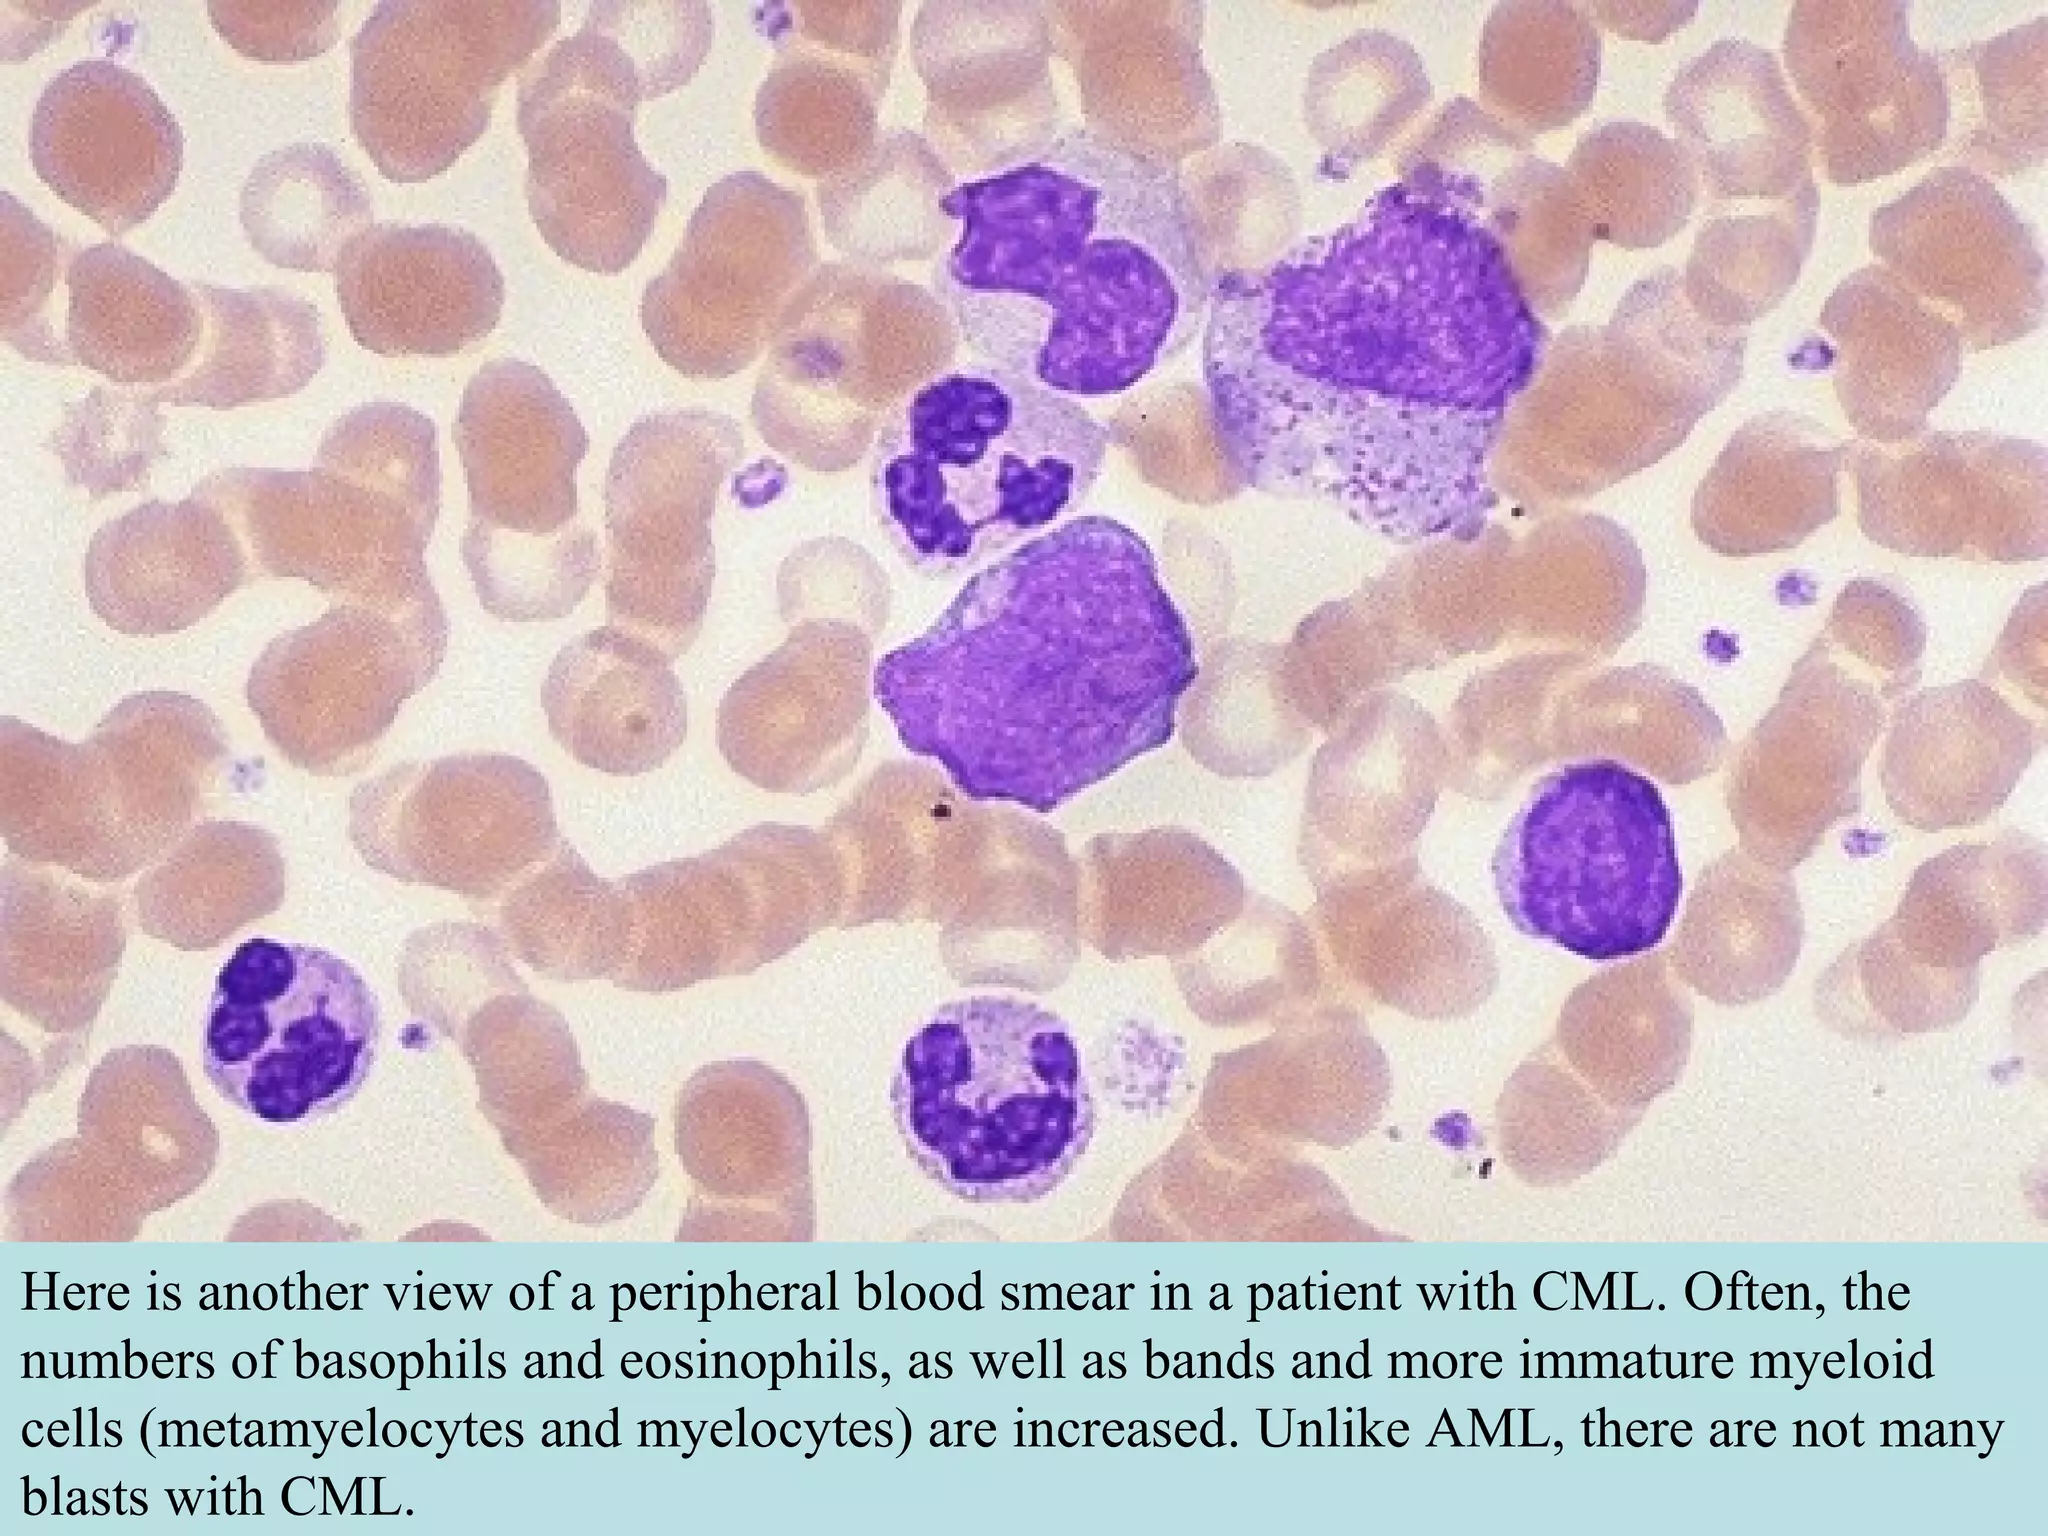
Here is another view of a peripheral blood smear in a patient with CML. Often, the
numbers of basophils and eosinophils, as well as bands and more immature myeloid
cells (metamyelocytes and myelocytes) are increased. Unlike AML, there are not many
blasts with CML.

This document discusses chronic leukemias and myeloproliferative disorders including chronic myeloid leukemia (CML) and myelofibrosis. CML is distinguished from other myeloproliferative disorders by the presence of the Philadelphia chromosome and BCR-ABL fusion gene. CML is characterized by leukocytosis, thrombocytosis, and anemia. It progresses through chronic, accelerated, and blast phases defined by increasing blast counts and symptoms. The massive spleen seen in CML is indicative of the underlying myeloproliferative process.

![LGL LeukemiaLGL Leukemia
Two types:
–T cell type [80%]
[CD 2,3,5,7,8,16, 56+ & 4, 57-]
–NK cell type](https://image.slidesharecdn.com/chronicleukemias-csbrp-151030075550-lva1-app6892/75/Chronic-leukemias-csbrp-40-2048.jpg)